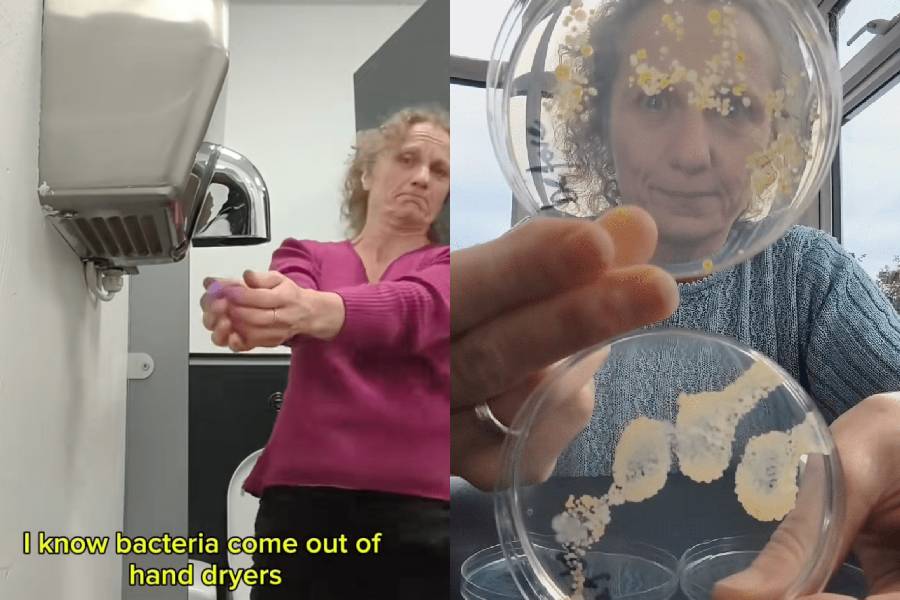

Read More
Ill-fitting bras may be a "hidden killer" for spine health
06-05-2026 12:00 HKT
Threads hot topic: Broccoli turns into "insect apocalypse"
05-05-2026 12:00 HKT

A British scientist’s simple petri-dish experiment has exploded online with over 10 million views, revealing that hot-air hand dryers in public restrooms spew clouds of bacteria and fungi onto freshly washed hands, while plain room air leaves plates nearly spotless.
Ruth MacLaren, founder of the educational group Devon Science, placed open culture dishes beneath a restroom dryer to capture its blast, then waved another through ordinary air as a control.
After an overnight incubation, the dryer sample bloomed with colorful colonies of microbes, whereas the control stayed virtually clean.
A follow-up test compared four surfaces: the dryer vent itself, restroom air, hands before washing, and hands after washing and drying. The vent harbored the heaviest load, but alarmingly, post-dryer hands carried even more germs than before they were washed.
The footage sparked instant panic across social media, with users swearing off dryers forever and pledging to wipe hands on clothing instead.
Some skeptics questioned the sample size and called for side-by-side trials with paper towels or air-drying alone.
Medical voices urged calm, stressing that thorough soap-and-water scrubbing followed by complete drying—however achieved—remains the gold standard for hygiene.
Though researchers still debate whether dryers truly recontaminate skin, MacLaren’s vivid demonstration has reignited everyday worries about restroom routines and sent millions rethinking that final blast of warm air.
Download The Standard app to stay informed with news, updates, and significant events: